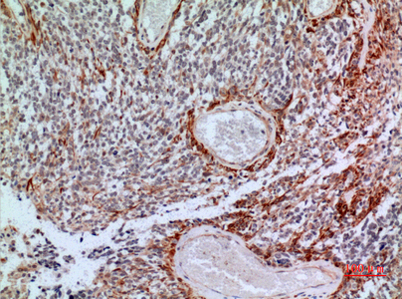

$148.00/50µL $248.00/100µL
| 50 µL | $148.00 |
| 100 µL | $248.00 |
| Product name: | CD200 rabbit pAb |
| Reactivity: | Human;Rat;Mouse; |
| Alternative Names: | CD200; MOX1; MOX2; My033; OX-2 membrane glycoprotein; CD200 |
| Source: | Rabbit |
| Dilutions: | Western Blot: 1/500 - 1/2000. IHC-p: 1/100-1/300. ELISA: 1/20000. Not yet tested in other applications. |
| Immunogen: | The antiserum was produced against synthesized peptide derived from the Internal region of human CD200. AA range:171-220 |
| Storage: | -20°C/1 year |
| Clonality: | Polyclonal |
| Isotype: | IgG |
| Concentration: | 1 mg/ml |
| Observed Band: | 31kD |
| GeneID: | 4345 |
| Human Swiss-Prot No: | P41217 |
| Cellular localization: | Cell membrane; Single-pass type I membrane protein. |
| Background: | This gene encodes a type I membrane glycoprotein containing two extracellular immunoglobulin domains, a transmembrane and a cytoplasmic domain. This gene is expressed by various cell types, including B cells, a subset of T cells, thymocytes, endothelial cells, and neurons. The encoded protein plays an important role in immunosuppression and regulation of anti-tumor activity. Alternative splicing results in multiple transcript variants encoding different isoforms. [provided by RefSeq, Jan 2016], |